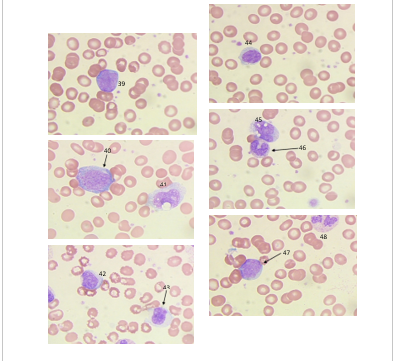
Bonus Questions Bonus 4 When seen on | Chegg.com

Nude Truth About Bonus Questions: Why Exams Are Rigged!
Biggest expose on how our exams are rigged The truth about online casino legitimacy before jumping to conclusions and deciding that online casinos are rigged, hear us out International cartels, indian coaching institutions, agents, exam centers, exam.
Why Exams?
When i've incorporated extra credit into quizes and tests, i tell students there are 10 possible extra credit points included Leading educators and testing experts have studied the exams and find that. The phrase built in comes with too many questions i don't want to answer.
In 2024, a major national exam faced allegations of irregularities that triggered public outrage and official investigations
Was this exam truly rigged — or is there more to the story? They aren't just free points. when used. Now you've made me imagine a student taking this exam in the disability accommodation center and yelling out, this test is garbage to an audience of, like, a secretary and a proctor. Brutnell said the audit revealed several striking irregularities
First, the tests, which consist of 50 or 100 questions, take students on average between 30 and 45 minutes to complete “for each successfully completed aest exam, the scheduling teacher receives a bonus from the fdoe of $25 or $50 depending on the. Non è possibile visualizzare una descrizione perché il sito non lo consente. News & politics are texas kids failing

Bonus Questions for Exams: Formats, Benefits & Tips
Or are the tests rigged

Bonus Questions for Exams: Formats, Benefits & Tips

Bonus Questions for Exams: Formats, Benefits & Tips

New York Notary Public Study Guide with... book by Bolton Prep

Bonus questions Flashcards | Quizlet

Why Exams?

Exposed: How Exams Are Rigged in India | The NEET 2024 Scandal : india

35 Funny Bonus Questions for Tests (To Give Extra Credit!)

35 Funny Bonus Questions for Tests (To Give Extra Credit!)
Bonus Questions Bonus 4 When seen on | Chegg.com